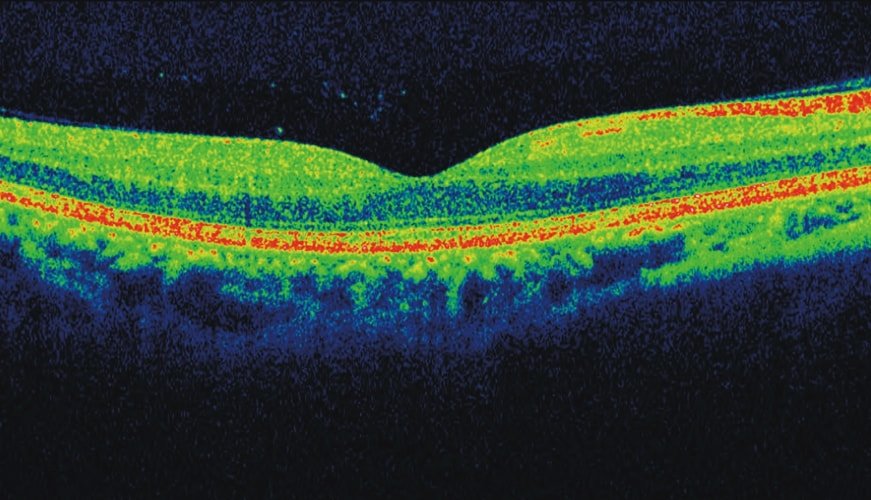

Od 1.6.2021 jsou všechna naše pracoviště vybavena přístrojem Zeiss Cirrus OCT 500 HD umožnujícím vyšetření zadního segmentu oka.
Optická koherentní tomografie (OCT) je neinvazivní, nekontaktní, transpupilární zobrazovací diagnostická metoda, která umožňuje provést a znázornit řezy sítnicí s vysokou rozlišovací schopností. Používá se především při poruchách sítnice, diagnostice makulárních chorob. Tedy u pacientů s cukrovkou, vysokým krevním tlakem, závažným dědičným očním onemocněním, věkem podmíněnou makulární degenerací.
Moderní diagnostické zařízení slouží k přesnému sledování změn na zrakovém nervu i sítnici, zvláště u zeleného zákalu /glaukomu/ a věkem podmíněných makulárních degenerací a jejich sledování v čase. Velkou výhodou je možnost 3D zobrazení struktur oka, které umožňuje provádět řezy „v kostce“ – různě s nimi otáčet.
Vyšetření na spektrálním OCT usnadní diagnostiku různých chorob a umožní rychlejší a správnější rozhodnutí k nasazení speciální léčby. Sledování v čase pak umožní hodnotit jak efektní je nasazená léčba, usnadní přesně indikovat aplikace léků do sklivce, dovoluje také indikovat chirurgické řešení určitých patologických stavů nitra oka. Spektrální OCT dovede vyšetřit i přední segment oka, především rohovku a komorový úhel. Lze provádět bezkontaktní pachymetrii - změření tloušťky rohovky i bezkontaktní měření šířky komorového úhlu zejména u zeleného zákalu, ale také poúrazových stavů a jejich hodnocení s odstupem času.
Díky tomuto vyšetření lze odhalit i počínající onemocnění sítnice, jež nebylo možné zachytit pomocí doposud dostupných metod vyšetření sítnice.
Pomocí OCT vyšetření oční specialista dokáže včas zachytit oční onemocnění jako jsou:
- věkem podmíněná makulární degenerace (VPMD)
- glaukomové onemocnění (zelený zákal)
- nádorová onemocnění oka
- otoky na sítnici u pacientů s cukrovkou
- makulární díru a další onemocnění oka
Vyšetření je nebolestivé, relativně krátké, není potřeba oko rozkapávat, takže pacient může potom odjet domů třeba autem. Výsledek vyšetření je vzápětí a to v podobě barevného přesného zobrazení všech vyšetřovaných struktur oka. I když je toto zobrazení velmi přesné, diagnóza z tohoto vyšetření se u některých onemocnění sítnice i zrakového nervu musí doplnit dalšími vyšetřeními. Lékař, který spektrální OCT vyhodnotí, pacienta vždy poučí a vysvětlí mu výsledek.
Protože toto vyšetření využívá optického paprsku a jeho odrazu, je neproveditelné u očí, které mají neprůhledná média – tedy rohovku, čočku nebo sklivec. Toto vyšetření vyžaduje také spolupráci pacienta – klid hlavy a očí při vyšetření.
Vyšetření na OCT není hrazeno ze zdravotního pojištění. Posílá na ně v indikovaných případech oční lékař po dohodě s pacientem. Na vyšetření se ale může objednat i sám pacient, který má zájem zjistit stav svých očí a jejich struktur. S ohledem na nenáročnost a šetrnost celého vyšetření je to skvělá možnost prevence.